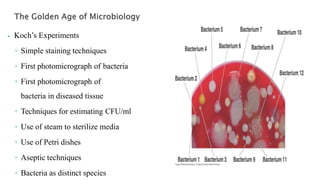
⦁ Koch’s Experiments
◦ Simple staining techniques
◦ First photomicrograph of bacteria
◦ First photomicrograph of
bacteria in diseased tissue
◦ Techniques for estimating CFU/ml
◦ Use of steam to sterilize media
◦ Use of Petri dishes
◦ Aseptic techniques
◦ Bacteria as distinct species

Embed presentation
Download to read offline








This document discusses the history and fields of microbiology. It describes Koch's early experiments that helped establish microbiology as a scientific discipline, including his use of staining techniques to visualize bacteria and development of methods to culture and study bacteria. The document also outlines key areas of microbiology including biochemistry, genetics, molecular biology, recombinant DNA technology, and gene therapy. It notes applications such as using microbes to study biochemical reactions, manipulating genes for practical uses like producing human blood clotting factors, and inserting genes to treat genetic diseases.